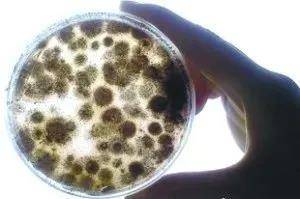
养殖业|霉菌毒素为什么是隐性杀手？看看它的这五大特点就知道

养殖业|霉菌毒素为什么是隐性杀手?看看它的这五大特点就知道( 二 )
文章图片
养殖场仓储
2)除了在田间、储存中、在养殖环节中(水线内、料槽内)也有很多细节被我们所忽略!(如下图)

文章图片
水碗内饲料变酸

文章图片
减压水箱污染

文章图片
鸡吐水或拉到料槽内

文章图片
料槽内饲料结块
2、普遍性
★通过以上分析可以看出 , 我们看不到的地方并不意味着没有霉菌感染 , 霉菌和霉菌毒素可以说是无处不在 , 尤其是在经常下雨比较湿润的南方地区 , 危害更大 。 如果玉米水分又在17%以上 , 更是容易发霉 。
★很多人认为霉菌也仅在多雨潮湿的夏季会比较多些 , 事实证明 , 秋冬季节一点也不少 , 尤其是新玉米刚下来的时候 , 湿度一般都比较大 , 天气又不利于晾晒 , 更容易发霉 , 尤其是东北玉米被冻整个冬天 。 这也充分解释了为什么即使在寒冷的冬季 , 肉鸡腺胃炎依然很多的原因 。 腺胃炎最早发生在对比!现在的高发地依然在东北!
★还有些地方 , 能用上国家粮库更换下来的陈化粮 , 陈化粮最大的弊端就是存放时间长 , 捂了霉了 , 人不能吃了 , 就全给动物吃 。
3、微量性(剧毒性)
文章图片
剧毒
★ 1、我们通常认为 , 饲料稍微有点霉变应该没事 , 不会引起中毒 , 所以也就不在意 。 有些养殖场认为 , 加不加脱霉剂都无所谓 , 白白增加成本 , 所以就不怎么加 , 有的人甚至一点都不加 。
★ 2、这是因为不知道霉菌毒素的安全水平是零!只要有极少的霉菌毒素的存在就会造成的伤害 , 而且这种危害会不断累积 , 最终总会表现出来 。
★ 3、1mg的黄曲霉素就可以导致癌症发生 , 一次性摄入20mg黄曲霉素直接致成年人死亡 , 属剧毒物范围 , 毒性比是敌敌畏的100倍、氰化钾的10倍 , 砒霜的68倍 。
★ 4、之所以家禽吃了发霉的饲料没有表现出症状 , 主要还是没有达到一定的量 , 还有就是肝脏的解毒功能 , 但是 , 如果经常吃 , 超出肝脏的极限之后呢!?(现在应该认识到保肝有多重要了吧)
★5、黄曲霉毒素是国际卫生组织认定的一级致癌物 , 其毒性和致癌性是所有霉菌毒素中最强的 , 也是肝脏的危害最大的
★而且在280度的高温下才能把黄曲霉毒素杀死 。
4、累积性
★少量的霉菌毒素虽然没表现出什么症状 , 但霉菌毒素具有累积效应 , 即使含量很低也会影响畜禽生长 , 因为霉菌毒素没有安全量或最低标准 。
★长期使用发霉的饲料 , 蓄积到一定程度 , 就会慢慢表现出各种症状 , 有的人直到症状明显 , 用别的药治疗无效时才意识到问题的严重性 , 才开始往霉菌上考虑 , 这个时候多半是有点晚了 , 因为霉菌毒素是直接伤害内脏器官 , 恢复起来太慢 , 有时候根本就恢复不过来 。
★正所谓“冰冻三尺非一日之寒” , 既然霉菌和霉菌毒素避无可避 , 就不应该等症状出现了在采取措施 , 一定要在平时就注重做“脱霉、解毒、保肝”等防控处理 , 把危害降到最低 。
★ 5、所以 , 长期添加脱霉剂 , 可降低动物的发病率和死亡率 , 减少腹泻 , 提高饲料转化率 , 这是养殖增效的最有效最经济实惠的途径 。
推荐阅读
- 毒素|热量堪比“喝油”的四种早餐,请及时拉黑,若爱吃,难怪瘦不下来
- 水发|豆腐和此物是天仙配,轻松排出肠胃毒素,皮肤变得又白又嫩
- 空腹|别再当零食吃了,空腹泡水喝一杯,排毒素清垃圾,肌肤更显年轻
- 子宫|女性不愿老太快,推荐常吃三种美食,排出毒素,预防子宫早衰
- 功效|女性晚上当零食吃几颗,排出毒素,失眠好了,气色越来越红润
- 物质|黄曲霉毒素检测仪生产厂家 智能型黄曲霉毒素检测仪生产厂家推荐
- 厨房|黄曲霉毒素很狡猾,如果你家里厨房有这5种情况,抓紧收拾
- 气血|女人怀孕后,4物敞开吃,或助你排出毒素,宝宝皮肤有好处
- 垃圾|黑木耳加一宝同炒,排毒素,清垃圾,眼睛明亮,会更干净!
- 人体|女性不想变老,常食3种食物,排出毒素,补血美容,促进血液循环











